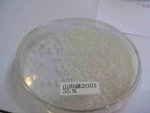
IMG_4426

| LamLand :: Sake Tasting - Mr. Okushima | |
|
Visits: 701 times
Last changed: Sep 10, 2008 56 items in this album |
|
www.fotop.net |
||
|
|
||||||||||
| [leave message] [email album] | ||
|
| ||
|
|
||||||||||
|
www.fotop.net |
||